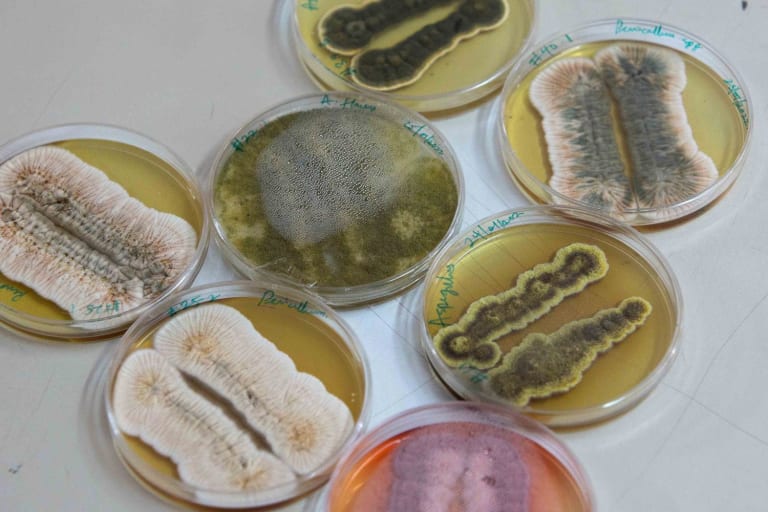

Aflatoxines: stille killers in voedsel
Wanneer dagelijkse kost levensgevaarlijk wordt

In de wijken rond Dandora, een enorme vuilnisbelt aan de rand van Naïrobi, verdienen afvalverzamelaars hun brood door elke dag urenlang plastic uit de afvalhopen te vissen.
© Johannes De Bruycker

In de wijken rond Dandora, een enorme vuilnisbelt aan de rand van Naïrobi, verdienen afvalverzamelaars hun brood door elke dag urenlang plastic uit de afvalhopen te vissen.
© Johannes De Bruycker
Olivia Kortas
25 augustus 2025 • 13 min leestijd
Stel je voor: je dagelijkse kost is plots dodelijk voedsel geworden omdat de ingrediënten niet correct opgeslagen werden. Het is een reëel risico in gebieden met een vochtig en warm klimaat. De boosdoeners heten aflatoxines: onzichtbare, smaakloze giftige stoffen.
Om vijf uur 's middags keert het leven terug in de straat waar Moses Orwaa zijn molen runt. Vrouwen bakken vis uit het Victoriameer, kinderen in schooluniformen lopen voorbij. Voor Orwaa, een man van midden vijftig met een witte jas en een veiligheidsbril, beginnen de drukste uren van de dag. Zijn maalmachine ratelt luid, de lucht in zijn houten schuur vult zich met meelstof.
Een vrouw komt binnen en laat twee kilo maïs malen. Een jongeman die de hele dag voetballen in elkaar heeft genaaid, koopt wat gemalen maniokmeel van Orwaa voor het avondeten met zijn familie. Steeds meer mensen verdringen elkaar in de molen, delen de laatste roddels en wachten op hun beurt.
Orwaa runt deze molen al sinds 1992 in Korogocho, een informele nederzetting in de Keniaanse hoofdstad Nairobi. Veel van zijn klanten houden het hoofd boven water met verschillende baantjes. Aan het eind van de dag hebben ze vaak maar net genoeg geld om een beetje maïs te kopen, het te laten malen en er ugali van te maken, een gekookte pap van maïsmeel die erg vullend is. ‘Ik wil de rest van mijn leven molenaar blijven,’ zegt Orwaa, ‘omdat ik ervoor kan zorgen dat mensen niet verhongeren, door ze maïs op krediet te verkopen.’
Maar molens zoals de zijne, waar mensen vaak hun eigen graan malen dat ze op de zwarte markt hebben gekocht, zijn potentieel gevaarlijke plekken. Onzichtbare, smaakloze giftige stoffen, bekend als aflatoxines, kunnen zich hier verspreiden. Die worden geproduceerd door bepaalde soorten schimmels onder stress.
In zeldzame gevallen leidt de inname van voedsel besmet met aflatoxines tot een snelle dood. Onderzoekers hebben ontdekt dat aflatoxines ook kankerverwekkend en schadelijk voor de lever zijn. Zelfs kleine doses over een langere periode kunnen leiden tot leverschade of leverkanker en tot ontwikkelingsproblemen bij kinderen.
Schimmels die aflatoxines kunnen produceren, tasten vooral graan- en notenoogsten aan. Ze verspreiden zich vooral in gebieden met een vochtig en warm klimaat: in Latijns-Amerika en Oost-Afrika. Maar door de klimaatcrisis kunnen aflatoxines binnenkort ook de oogsten van boeren in Centraal- en Zuid-Europa bederven.

Moses Orwaa aan het werk in zijn molen in Karogocho, Naïrobi.
© Johannes De Bruycker
Moses Orwaa zegt dat hij in 1998 voor het eerst over aflatoxines hoorde in een televisiereportage. ‘De regering waarschuwde dat iets onze maïs aan het vergiftigen was’, herinnert hij zich. De volgende dag kwam hij samen met de andere molenaars in de buurt. ‘We bespraken dat we geen gevaarlijke maïs moesten importeren, zodat we het spul niet naar ons toe konden halen.’
Het grootste probleem voor molenaars zoals Orwaa is dat aflatoxines geur- en smaakloos zijn. Besmette maïs kan vaak niet met het blote oog worden gedetecteerd als de schimmels zich alleen binnen in een korrel verspreiden. Bovendien is de apparatuur die gebruikt kan worden om de maïs te testen erg duur.
Orwaa zegt dat zijn klanten soms bezorgd zijn en hun maïs terugsturen als ze schimmelsporen ontdekken. Hij vervangt die dan. Sinds kort koopt hij zijn maïs van vier boeren in Centraal-Kenia, voordien kocht hij het van buurland Oeganda. Maar de Keniaanse overheid heeft een paar maanden geleden de import uit Oeganda verboden omdat te veel maïs besmet was met aflatoxines.
Orwaa’s klanten kopen hun maïs goedkoop op informele markten, en net daar verspreidt besmette maïs zich vaak. Mensen nemen het risico als het enige alternatief honger is. ‘Natuurlijk ben ik bang dat mijn maïs ook gevaarlijk kan zijn’, zegt Orwaa.
Uitbraken
Kenia wordt al lange tijd beschouwd als aflatoxine-hotspot. De eerste gedocumenteerde grote uitbraak van aflatoxine dateert van 1981. Maar mensen herinneren zich vooral de dodelijke uitbraak in 2004 in de regio Kitui. Daar vergiftigde besmette maïs meer dan 300 mensen. Meer dan een derde van hen stierf aan de gevolgen.
Slechts een jaar later was er een andere, iets kleinere uitbraak in dezelfde regio. Mutava Nyamai, een maïsboer uit een dorp in Kitui, verloor binnen een week zijn vierjarige dochter en zijn zwangere vrouw.
Op een warme dag begin 2022 bezoeken we Nyamai, een lange man in een overhemd. Hij loopt over zijn velden naar het verlaten huis waar hij destijds met zijn gezin woonde. Zijn dochter en vrouw liggen begraven onder de bomen. ‘Het zou een zoon geweest zijn,’ zegt Nyamai over het ongeboren kind.

Maïsboer Mutava Nyamai verloor in één week zijn vierjarige dochter en zwangere vrouw aan aflatoxinevergiftiging. ‘Ze aten ugali, zoals elke avond,’ zegt hij. ‘De volgende dag werden ze ziek. Zes dagen later waren ze allebei dood.’
© Johannes De Bruycker
Het gezin at ugali met groenten voor het avondeten, zoals ze bijna elke avond deden. De volgende dag begon de vierjarige symptomen te vertonen. ‘Het begon met hoofdpijn, toen zwollen haar gewrichten op, haar buik zwol op en ze had etter in haar ontlasting en urine’, zegt Nyamai. Hij bracht haar naar het ziekenhuis, waar de artsen aanvankelijk aan malaria dachten. Zes dagen lang vreesde hij voor het leven van zijn dochter. Geen enkele hulp kon baten.
‘Toen ik thuiskwam, trof ik mijn vrouw aan met dezelfde symptomen’, vertelt hij. Nyamai herinnert zich hoe hij haar naar de kant van de weg droeg en tot de middag moest wachten op een lift naar het ziekenhuis. ‘Ze stierf onderweg’, zegt hij. ‘Ik stapte uit, legde haar aan de kant van de weg en bracht haar toen naar huis.’ Pas toen realiseerden de ambtenaren in het gebied zich dat het weer om een aflatoxinecrisis ging.
Resistente pinda’s
Uitbraken zoals die in Kitui trokken de aandacht van Keniaanse onderzoekers. In 2004 besloot mycotoxicologe Sheila Okoth haar onderzoek te richten op aflatoxines om te voorkomen dat soortgelijke uitbraken opnieuw zouden plaatsvinden. ‘Ik had de expertise en dacht: waarom niet? Ik moet mijn mensen helpen’, zegt de energieke, 60-jarige vrouw in onderzoeksjas. Ze werkt samen met een aantal technici en studenten in een klein gebouw op het terrein van de faculteit Biologie van de prestigieuze universiteit van Nairobi. Zij en haar team zijn op zoek naar soorten pinda's die resistent zijn tegen ziekten en schimmelaantastingen om de verspreiding van aflatoxines tegen te gaan. Niet alle planten- en graansoorten zijn namelijk op dezelfde manier gevoelig voor schimmelaantasting.
Granen met schimmelsporen consumeren is relatief onschadelijk voor de gezondheid. Het wordt pas gevaarlijk als die schimmels aflatoxines geproduceerd hebben. ‘We geloven dat de productie van toxines een beschermingsmechanisme van de schimmels is’, legt Okoth uit. De toxines zijn zogenaamde secundaire metabolieten, dat wil zeggen: producten die de schimmels niet nodig hebben voor hun eigen voortplanting of voor hun groei – kortom, om onder goede omstandigheden te overleven. Alleen een bepaalde stijging in temperatuur en vochtigheid stimuleert de productie van aflatoxine. En die kan op elk punt in de productieketen gebeuren, vaak op slechts een paar dagen tijd: op de boerderij, tijdens de oogst of tijdens de opslag. Daarom is het belangrijk dat de maïs na de oogst voldoende gedroogd en later op een droge, koele plaats opgeslagen wordt.
Maar de klimaatcrisis maakt het moeilijk voor kleine Keniaanse boeren om gewassen goed te drogen. Vroeger was het weer cyclisch: boeren wisten precies wanneer het zou regenen en wanneer niet en stemden hun zaaien en oogsten daarop af. Maar de afgelopen vijftig jaar is het klimaat in Kenia veranderd. De minimum- en maximumtemperaturen zijn in het hele land, met uitzondering van de kustgebieden, sterk gestegen. Daardoor komt extreem weer vaker voor.

Professor Sheila Okoth leidt het onderzoek naar resistente gewassen en veilige opslagmethoden.
© Johannes De Bruycker
Veel regio's hebben te kampen met droogte tijdens het droge seizoen, terwijl andere overstromingen op hun bord krijgen in het regenseizoen. De regenval is onvoorspelbaar geworden. Plotselinge regen doorweekt vaak de maïs, die de boeren na de oogst enkele dagen in de zon te drogen leggen. Als het vocht in de korrels blijft zitten, creëert dat gunstige omstandigheden voor de ontwikkeling van aflatoxines.
Maïs gaat in Kenia door vele handen voordat het de consument bereikt. De meeste boeren hebben kleine boerderijen en verkopen hun overtollige oogst aan tussenhandelaren. Die laten de verzamelde maïs vermalen in grote molens. Ook daar kan aangetaste maïs andere maïs contamineren. Onderzoekster Sheila Okoth zou daarom graag zien dat de Keniaanse regio’s gecentraliseerde droog- en opslagsystemen beschikbaar stellen voor alle boeren.
‘De boeren zouden dan een document krijgen waarop staat dat ze bijvoorbeeld honderd zakken afgeleverd hebben, die ze op elk moment weer kunnen ophalen, tegen een kleine vergoeding’, verduidelijkt ze. ‘Dat zou de makkelijkste manier zijn om vocht onder controle te houden.’ Volgens haar ligt de verantwoordelijkheid voor zo’n systeem bij politici: ‘We kunnen alle expertise hebben die we willen. Maar als we de zegen van de regering niet hebben, is het een idee voor de prullenmand.’
Politici geven er niet genoeg om, vindt Okoth, en daarom ziet ze educatie als een belangrijk onderdeel van haar werk. Ze onderzoekt aflatoxines samen met boeren en hoopt hen op deze manier te sensibiliseren. De boeren met wie ze heeft samengewerkt, zijn volgens haar voorzichtiger geworden. Ze zorgen ervoor dat hun maïs niet doorweekt raakt. Okoth en haar team reizen ook naar dorpen, ontmoeten daar de leiders van de gemeenschap en praten over aflatoxines. ‘Diep in het binnenland komen we nog steeds mensen tegen die er nog nooit van gehoord hebben, maar ze vertellen ons wel over incidenten. Ze zijn vaak geschokt als ze horen dat het gevaar onder controle kan worden gehouden en dat de dood niet het gevolg was van magie maar van vergiftiging.’
Er zijn ook radicalere benaderingen, bijvoorbeeld een product dat Aflasafe heet. Het verspreidt een schimmel in de grond die geen gifstoffen kan produceren en die het leefgebied van gevaarlijke schimmels wegneemt. Keniaanse boeren gebruiken Aflasafe nog maar een paar jaar, en er is nog geen onderzoek gedaan naar de effecten op lange termijn.
Bij een andere bestrijdingsmethode worden stoffen aan de maïs toegevoegd om de giftige stoffen te binden. Op die manier worden ze niet door de darmen opgenomen als mensen besmette maïs eten. Momenteel worden onderzoeken uitgevoerd op gevogelte.
Samenwerking tussen verschillende landen en belanghebbenden is belangrijk om de verspreiding van aflatoxines onder controle te krijgen, benadrukt Sarah De Saeger, directeur van het Excellentiecentrum voor Mycotoxicologie en Volks-gezondheid aan de Universiteit Gent. De Belgische mycotoxicologe coördineert Up-Rise, een Horizon Europa-project van de Europese en Afrikaanse Unie. Het onderzoeks-
project werkt onder andere met handelaars op informele markten in Kenia, Ivoorkust, Benin, Nigeria en Zuid-Afrika.
Samen met de partners onderzoeken de wetenschappers of bijvoorbeeld maïs of gierst veiliger zijn als ze worden gefermenteerd. ‘Gefermenteerd voedsel is een populair onderdeel van sommige Afrikaanse keukens, en we onderzoeken hoe dit proces de vorming van aflatoxines beïnvloedt’, legt De Saeger uit. De wetenschapster benadrukt dat er dankzij het onderzoek al veel kennis beschikbaar is over veilige opslag- en teeltmethoden.
Aflatoxinen, kankerverwekkende gifstoffen geproduceerd door schimmels, bedreigen de voedselveiligheid in Kenia. Onderzoekers analyseren besmette maïs in laboratoria om de verspreiding van deze gevaarlijke stoffen beter te begrijpen en te bestrijden.
© Johannes De Bruycker
In Europa
Aflatoxines zijn ook in Europa een terugkerend probleem. In juli 2024 werden nog potjes babyvoeding van twee Duitse biologische merken uit de rekken gehaald nadat bij tests verhoogde gehaltes van een aflatoxine waren aangetroffen. De klimaatcrisis vergroot ook het risico dat aflatoxines gewassen in Centraal- en Zuid-Europa besmetten.
Volgens een onderzoeksrapport dat in 2016 verscheen in het prestigieuze tijdschrift Nature zullen de gevaarlijke schimmels zich verspreiden in Zuid- en Oost-Europa als de gemiddelde temperatuur wereldwijd met 2 graden Celsius boven het pre-industriële niveau uitstijgt. En dat is een waarschijnlijk scenario.
Een bijzonder hete zomer leidde in 2012 tot een toename van aflatoxine in de maïsoogst in Servië. Als gevolg daarvan werden in Servische melk hoge aflatoxinegehaltes gevonden die de EU-limiet overschreden. Er werden ook aflatoxines gevonden in oogsten in Griekenland, Spanje en Italië.
Vandaag worden vooral mensen in armoede blootgesteld aan het risico van aflatoxines. Dat is te zien in Nairobi, de rijkste stad van Oost-Afrika, waar de ongelijkheid extreme vormen heeft aangenomen. In de wijken rond Dandora, een enorme vuilnisbelt aan de rand van Nairobi, verdienen afvalverzamelaars hun brood door elke dag urenlang plastic uit de afvalhopen te vissen. Aan het eind van de dag hebben ze net genoeg geld voor wat maïsmeel van de zwarte markt, dat volgens onderzoeken vaak besmet is met aflatoxines. Maar als je deze vrouwen of de klanten van molenaar Moses Orwaa vraagt wat ze zouden eten als ze het zonder ugali moesten doen, zie je verbijsterde gezichten.
Dit artikel werd gerealiseerd met de steun van de Memento Media Prijs.
Deze reportage werd geschreven voor MO*156, het zomernummer van MO*magazine. Vind je dit artikel waardevol? Word dan proMO* voor slechts 4,60 euro per maand en help ons dit journalistieke project mogelijk maken, zonder betaalmuur, voor iedereen. Als proMO* ontvang je het magazine in je brievenbus én geniet je tal van andere voordelen.
Word proMO*
Vind je MO* waardevol? Word dan proMO* voor slechts 4,60 euro per maand en help ons dit journalistieke project mogelijk maken, zonder betaalmuur, voor iedereen. Als proMO* ontvang je het magazine in je brievenbus én geniet je van tal van andere voordelen.
Je helpt ons groeien en zorgt ervoor dat we al onze verhalen gratis kunnen verspreiden. Je ontvangt vier keer per jaar MO*magazine én extra edities.
Je bent gratis welkom op onze evenementen en maakt kans op gratis tickets voor concerten, films, festivals en tentoonstellingen.
Je kan in dialoog gaan met onze journalisten via een aparte Facebookgroep.
Je ontvangt elke maand een exclusieve proMO*nieuwsbrief.
Je volgt de auteurs en onderwerpen die jou interesseren en kan de beste artikels voor later bewaren.
Per maand
€4,60
Betaal maandelijks via domiciliëring.
Meest gekozen
Per jaar
€60
Betaal jaarlijks via domiciliëring.
Voor één jaar
€65
Betaal voor één jaar.
Ben je al proMO*
Log dan hier in:format(png))